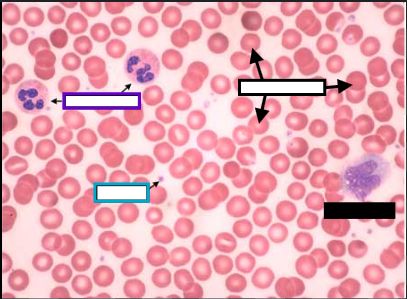
<p>What is the purple box arrow pointing at?</p>

1/9
Name | Mastery | Learn | Test | Matching | Spaced |
|---|
No study sessions yet.

What vessel is on the left? (NOT IN ANATOMICAL)
Artery

What vessel is on the right? (NOT IN ANATOMICAL)
Vein

Tunica Intima

Tunica Media

Tunica Externa

What is the black box arrow pointing at?
erythrocyte
What is the purple box arrow pointing at?
neutrophil

What is the blue box arrow pointing at?
platelet

What disease is shown on the slide?
sickle cell anemia

What disease is shown on the slide?
leukemia